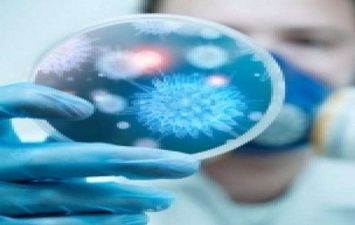
كابوس كورونا

ارتفع عدد المصابين بفيروس كورونا في الصين إلى 571 شخصا، بينهم 95 وصفت حالتهم بالخطرة.
وقد تأكد في وقت سابق وفاة 17 شخصا جراء الإصابة بالفيروس، جميعهم في إقليم هوبي بوسط الصين، وانتشر الفيروس في 25 ولاية ومدينة، وتم تسجيل خلال الأربع والعشرين ساعة الماضية 131 إصابة.
وأعلنت منظمة الصحة العالمية أن الإجراءات التي اتخذتها السلطات الصينية في ووهان، المدينة الواقعة في وسط البلاد، والتي سجلت فيها أول إصابة بفيروس كورونا المستجد، "ستحد" من مخاطر انتشار هذا الفيروس عالميا.
وبعد اكتشاف المرض في اليابان وكوريا الجنوبية وتايلاند وتايوان، سجّلت أول إصابة في الولايات المتحدة الثلاثاء الماضي، لرجل ثلاثيني متحدر من مدينة ووهان الصينية ويعيش في سياتل بشمال غربي الولايات المتحدة.
وهذا الفيروس هو نوع جديد من عائلة فيروسات الكورونا، التي قد تسبب أمراضا غير مؤذية لدى الإنسان كالزكام، لكنها قد تكون مصدر أمراض قاتلة مثل الالتهاب الرئوي (السارس).